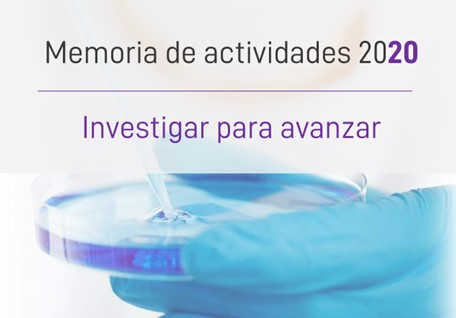
Imagen relativa a la noticia indicada

Resto de noticias, visualizando página 156 de 251

Compartimos con los profesionales de la neurología los retos en el acceso a tratamiento
Fecha de publicación:
Entre el 22 de noviembre y el 2 de diciembre se celebra la Reunión Anual de la Sociedad Española de Neurología celebrará en 2021 su 73ª edición en formato virtual, en la que trasladaremos los retos...

Finaliza la campaña “Un baño de Solidaridad” para luchar contra las enfermedades raras
Fecha de publicación:
El Silken Al-Andalus finaliza este año la sexta edición de la ya tradicional campaña “un baño de Solidaridad” a favor de la Federación Española de Enfermedades Raras, sólo interrumpida el pasado 2020...

Las enfermedades raras, una prioridad para los ministros de salud de Iberoamérica
Fecha de publicación:
Las Enfermedades Raras se han incorporado en la Declaración fruto de la XVI Conferencia iberoamericana de Ministros y Ministras de Salud que tuvo lugar el pasado jueves 28 de octubre de forma online...

Inauguramos el curso 'Singulares' sobre enfermedades raras dirigido a farmacéuticos y gestores hospitalarios
Fecha de publicación:
El curso ha sido inaugurado por nuestro presidente Juan Carrión.

XIV Congreso Internacional de ER: la importancia de una Resolución de las Naciones Unidas
Fecha de publicación:
Nuestra directora Alba Ancochea trasladará en el XIV Congreso Internacional de Enfermedades Raras organizado por D’Genes y la Universidad Católica San Antonio de Murcia la necesidad de una Resolución...

Ponemos en valor el trabajo en red entre entidades en el II Congreso de la Asociación Española de Enfermos de Pompe
Fecha de publicación:
La Asociación Española de Enfermos de Pompe celebró los pasados 29 y 30 de octubre su II Congreso de la Asociación Española de Enfermos de Pompe, un espacio en el que pusimos en valor la alianza que...
Comunidad autónoma/Provincia:Sevilla

Más de 240 menores con EPF o necesidades especiales, atendidos por el Sistema de Protección
Fecha de publicación:
Más de 240 menores con enfermedades poco frecuentes, en proceso de diagnóstico y/o necesidades especiales se encuentran atendidos por el Sistema de Protección a la Infancia en situación de...
La Fundación FEDER, clave para impulsar la investigación en enfermedades raras en plena pandemia
Fecha de publicación:
Nota de prensa: La Fundación de la Federación Española de Enfermedades Raras (Fundación FEDER) ha publicado su Memoria de Actividades 2020 coincidiendo con su XV aniversario y poniendo de relieve el...

Foros de ER: un análisis en profundidad para identificar retos junto a la comunidad profesional
Fecha de publicación:
Tenemos el placer de presentaros uno de los proyectos más ilusionantes de esta recta final del año como son nuestras Jornadas de Enfermedades Raras en 7 Comunidades Autónomas

Unidos por la suficiencia de plasma
Fecha de publicación:
Comunicado: Los representantes de la Asociación Española de Déficit Inmunitarios Primarios (AEDIP), la Asociación de Pacientes con Déficit de Alfa-1 Antitripsina (Alfa-1 España), la Federación...

Implicamos al Real Patronato de Discapacidad en la campaña “12 Razones, 12 Valores”
Fecha de publicación:
Representantes de CERMI Extremadura y del CERMI Estatal han presentado al Real Patronado de Discapacidad la iniciativa “12 Razones, 12 Valores: Constelaciones colectivas”, una campaña pública...
Comunidad autónoma/Provincia:Extremadura

‘Asume un reto científico’ para motivar una nueva generación de investigadores de ER
Fecha de publicación:
De las más de 6.172 enfermedades raras identificadas en todo el mundo, sólo el 20% están siendo investigadas, lo que condiciona su diagnóstico, tratamiento y abordaje social y sanitario. Con el fin...

